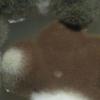
message #65644

11-04-2026 15:45
Zuzana Sochorová (Egertová)
Please, could anyone send me this paper?Moyne G.,
11-04-2026 13:34
Artem PtukhaHello, I am seeking assistance with the identific
11-04-2026 10:19
Michel Hairaud
Chers amis d'Ascofrance , voici une très bonne no
11-04-2026 10:10
Michel Hairaud
Dear Ascofrance members, here is some very good ne
10-04-2026 23:22
Gernot FriebesHi,ascospores are 1- to 3-septate, approximately
10-04-2026 15:51
William Slosse
Hello everyone, On 08/04/26, I found a growth sit
09-04-2026 15:25
Jac GelderblomOn bare soil between mosses Ifound an asco I deter
09-04-2026 13:55
Thomas Læssøehttps://svampe.databasen.org/observations/10589176
09-04-2026 10:12
Thomas Læssøehttps://svampe.databasen.org/observations/10587061
Slow-growing chocolate brown colonies
Stephen Martin Mifsud,
30-10-2020 13:10
Colonies chocolate brown, growing very slowly on at 22C, velvety and smooth, excreting a light reddish brown pigment in PDA.Fungus composed of a densely and profusely branched mycelium, interwoven and without evident condiophores, but covered by mass of spores.
Vegetative mycelia septate, irregularly bent, curved, or kinked. Thickness not uniform about 2-4 um; terminal hyphae blunt-tipped; walls of some hyphae course and roughened by small tubercles, other hyphae relatively smooth, vacuoles present making hyphal content appear with several dark blobs and irregular.
Spores in short chains, then they break loose, sub globular (or angular?), sometimes rectangular (two merged spores), surface appearing finely pitted, 2-3um wide. Conidigenesis appearing budding from certain points along the mycelium without an evident or specialized spore-bearing structures.
I was associating it with Wallemia, but the habitat does not match because this was collected by a sterile disposable loop from surface of glass in a museum!!!!
David Malloch,
30-10-2020 14:06
Re : Slow-growing chocolate brown colonies
Hello Stephen..
I believe you are correct in calling it Wallemia. Perhaps the conidia came from elsewhere and were just stuck to the glass.
David
I believe you are correct in calling it Wallemia. Perhaps the conidia came from elsewhere and were just stuck to the glass.
David
Joey JTan,
31-10-2020 02:49
Re : Slow-growing chocolate brown colonies
Wallemia is xerophilic and quite common in indoor environments - I can imagine there would be plenty of conidia on surfaces in a humidity-controlled museum.
Stephen Martin Mifsud,
31-10-2020 21:55
Re : Slow-growing chocolate brown colonies
Many thanks David an Joey for your kind replies. I am impressed about this finding. I try to narrow it down to species level if I find literature about this genus.
To tell you a bit more I swabbed (with a disposable loop) 4 plates, two plates from a glass cabinet were evident was the brown , slow-growing colonies of Wallemia, and two plates swabbed from a wall mounted sheet of glass where i have a white small-growing colonies at the centre of the plate (very mild no contamination) and one with Pencillium-like colonies dispersed on the plate (possibly contamination).
Many thanks dear colleagues
Stephen
To tell you a bit more I swabbed (with a disposable loop) 4 plates, two plates from a glass cabinet were evident was the brown , slow-growing colonies of Wallemia, and two plates swabbed from a wall mounted sheet of glass where i have a white small-growing colonies at the centre of the plate (very mild no contamination) and one with Pencillium-like colonies dispersed on the plate (possibly contamination).
Many thanks dear colleagues
Stephen